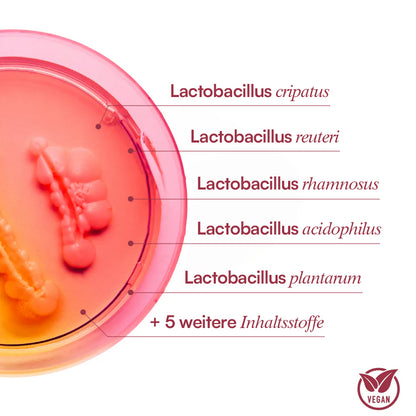
Vaginal Health Complex

-

Vegan
-

Frei von Gentechnik
-

Ohne Zuckerzusatz
-

Versand aus Europa
-

GMP-konform produziert
-

Laborgeprüft

Warum der Vaginal Health Complex⁺ anders wirkt
Lebende Kulturen
5 ausgewählte Lactobacillus-Kulturen mit insgesamt
10 Milliarden KBE pro Tagesportion.
Enthaltene Stämme:
- Lactobacillus crispatus
- Lactobacillus rhamnosus
- Lactobacillus acidophilus
- Lactobacillus plantarum
- Lactobacillus reuteri
Lactobacillus-Kulturen gehören zur Familie der Milchsäurebakterien
und sind seit Jahrzehnten Gegenstand mikrobiologischer Forschung.
FOS-Präbiotika
Fructooligosaccharide — kurz FOS — sind nicht-verdauliche Kohlenhydrate aus pflanzlichen Quellen und ein klassischer Bestandteil moderner Mikrobiom-Formulierungen. In Vaginal Health Complex⁺ ergänzen sie die lebenden Kulturen als ballaststoffähnliche Komponente und werden seit Langem in der Lebensmittelindustrie verwendet.
Milchsäure
L-(+)-Milchsäure ist eine im menschlichen Körper natürlich vorkommende organische Säure, die auch in fermentierten Lebensmitteln wie Joghurt oder Sauerkraut enthalten ist. In Vaginal Health Complex⁺ verwenden wir sie in mikroverkapselter Form — ein modernes Verfahren aus der Lebensmitteltechnologie, bei dem der Wirkstoff in einer dünnen pflanzlichen Schicht eingeschlossen wird, um ihn bis zur Einnahme stabil zu halten.
Cranberry-Extrakt
Der Vaginal Health Complex⁺ enthält 200 mg Cranberry-Extrakt mit standardisiertem PAC-Gehalt (Proanthocyanidine, 50 %), gewonnen aus der nordamerikanischen Moosbeere Vaccinium macrocarpon, kombiniert mit 200 mg D-Mannose — einem einfachen Zucker, der in vielen Pflanzen wie Birken, Lärchen, Apfel oder Pfirsich natürlich vorkommt. Beide Zutaten werden seit Jahrzehnten in Nahrungsergänzungsmitteln und Wellness-Produkten eingesetzt.
Vitamine & Mineralstoffe
Drei sorgfältig dosierte Mikronährstoffe
Der Vaginal Health Complex⁺ wird mit drei gezielt ausgewählten Mikronährstoffen ergänzt: 25 µg Vitamin D3 (Cholecalciferol), 300 µg RE Vitamin A (als Retinylacetat) und 7,5 mg Zink (in der gut verfügbaren Bisglycinat-Form). Vitamin A trägt zur Erhaltung normaler Schleimhäute bei.* Vitamin D und Zink tragen jeweils zu einer normalen Funktion des Immunsystems bei.*
* Gesundheitsbezogene Angabe gem. VO (EU) Nr. 432/2012
12 Inhaltsstoffe in einer durchdachten Formel.
Klicke einfach auf den jeweiligen Inhaltsstoff um mehr über Wirkung, Studien und Anwendung zu erfahren
-

Lactobacillus crispatus
Eine Lactobacillus-Kultur, die seit Jahrzehnten Gegenstand mikrobiologischer Forschung ist.
-

Lactobacillus rhamnosus
Einer der weltweit am häufigsten verwendeten Lactobacillus-Stämme in Nahrungsergänzungsmitteln.
-

Lactobacillus acidophilus
Ein klassischer Vertreter der Milchsäurebakterien, seit über 100 Jahren in der Wissenschaft bekannt.
-

Lactobacillus plantarum
Eine vielseitige Kultur, die natürlich auch in
fermentierten Lebensmitteln wie Sauerkraut vorkommt. -

Mikroverkapselte Milchsäure
L-(+)-Milchsäure in mikroverkapselter Form. Eine im menschlichen Körper natürlich vorkommende organische Säure.
-

Pflanzliche HMPC Kapselhülle
Pflanzliche Kapselhülle aus Hydroxypropylmethylcellulose (HPMC), frei von tierischer Gelatine.
-

Zwei Kapseln einmal täglich
-

Zu jeder Tageszeit
-

Nach einer Mahlzeit
-

Kein Grund zur Kühlung
Häufig gestellte Fragen
01 Wie wird Vaginal Health Complex eingenommen?
Nimm einfach 2 Kapseln täglich, nach einer Mahlzeit, ein.
Du kannst die Kapsel zu jeder Tageszeit einnehmen, wie es dir am besten passt.
02 Enthält es Hormone?
Nein, es handelt hierbei um ein Probiotikum mit 5 verschiedenen Bakterienstämmen und ohne jeglichen Hormonen.
03 Wie lange dauert es, bis ich eine Veränderung spüre?
Die meisten unserer Kunden berichten von spürbaren Verbesserungen nach ca. 2-3 Monaten.
Um Resultate zu spüren, ist eine kontinuierliche Einnahme ohne längere Unterbrechungen sehr wichtig.
04 Wie lange dauert der Versand und von wo wird versendet?
Alle Produkte werden aus unserem Lager in Polen versendet. Die Lieferzeit setzt, sind auch 2 verschiedenen Zeiten zusammen:
1) Bearbeitungszeit:
24-48 Stunden
2) Versandzeit:
Deutschland: 1-3 Werktage
Österreich: 3-5 Werktage
Schweiz: 3-5 Werktage
05 Wie lange kann ich retournieren?
Wir bieten eine risikofreie 100 Tage Geld Zurück Garantie auf alle Bestellungen an. Falls du unzufrieden bist schreib und einfach eine e-mail an info@purefemm.com und lass es uns gut machen.
06 Gibt es Nebenwirkungen?
Zum jetzigen Zeitpunkt sind uns keine Nebenwirkungen bekannt, falls du jedoch jegliche Nebenwirkungen entwickeln solltest, konsultiere einen Arzt und stoppe die Einnahme.
07 Kann ich es in der Schwangerschaft oder Stillzeit einnehmen?
Wenn du schwanger bist oder stillst, sprich bitte vor der Einnahme mit deinem Arzt.
08 Wie nehme ich die Kapseln ein? Zusammen oder getrennt?
Du kannst beide Kapseln gleichzeitig nach einer Mahlzeit einnehmen, wie es dir am besten passt.
Oder du teilst sie auf – z. B. eine morgens, eine abends. Wichtig ist nur, dass du sie täglich nimmst.
09 Kann ich die Kapsel öffnen und nur das Pulver einnehmen?
Wir empfehlen, die Kapsel im Ganzen einzunehmen. Sie schützt die Bakterien und sorgt für optimale Wirkung.
Wenn du Probleme beim Schlucken hast, sprich bitte mit deinem Arzt.
10 Ist der Vaginal Health Complex geeignet bei Histaminintoleranz?
Wenn du eine Histaminintoleranz hast, sprich vor der Einnahme mit deinem Arzt.
Wir achten zwar auf verträgliche Inhaltsstoffe, können aber keine individuelle Verträglichkeit garantieren.